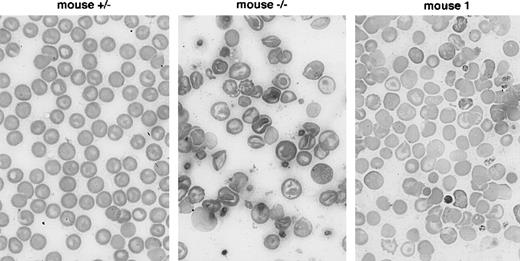
Fig. 3. Improvement of peripheral red blood cell morphology in treated β-thalassemic mice. / May-Grünwald Giemsa staining of blood smears from an untreated heterozygous mouse, from an untreated β-thalassemic mouse, and from the β-thalassemic mouse No. 1 twelve months after intramuscular injection of the rAAV-CMV-Epo vector.

β-Thalassemias are highly prevalent genetic disorders that can cause severe hemolytic anemia. The main pathophysiologic feature of β-thalassemia is the accumulation of unpaired -globin chains in erythrocyte precursors and red blood cells (RBCs). This accumulation alters cell membrane function and results in early cell destruction and ineffective erythropoiesis. Correction of globin chain imbalance through the induction of fetal hemoglobin (HbF) synthesis is a tentative therapeutic approach for this class of diseases. In short-term in vitro or in vivo assays, recombinant human erythropoietin increases the frequency of erythroid precursors programmed to HbF in humans and to β-minor globin in mice. In contrast, long-term treatment of β-thalassemic patients did not induce HbF significantly. We took advantage of highly efficient adeno-associated virus–mediated (AAV-mediated) gene transfer into mouse muscle to induce a robust and sustained secretion of mouse erythropoietin in β-thalassemic mice, which represent a suitable model for human β-thalassemia intermedia. A 1-year follow-up of 12 treated animals showed a stable correction of anemia associated with improved RBC morphology, increased β-minor globin synthesis, and decreased amounts of -globin chains bound to erythrocyte membranes. More effective erythropoiesis probably accounted for a reduction of erythroid cell proliferation, as shown by decreased proportions of circulating reticulocytes and by reduced iron 59 (59Fe) incorporation into erythroid tissues. This study indicates that the continuous delivery of high amounts of autologous erythropoietin induced a sustained stimulation of β-minor globin synthesis and a stable improvement of erythropoiesis in the β-thalassemic mouse model.
Thalassemias are the most common monogenic diseases. They are highly prevalent in the Mediterranean area, where Cooley's anemia was first recognized, and in Southeast Asia, where there are presumably more than 1 million severely affected individuals. β-Thalassemias are due to deficient β-globin synthesis, which causes globin chain imbalance in erythroid cells. Unmatched α-globin chains liberate iron,1 bind to membranes, and alter membrane lipids and proteins through oxidative mechanisms, thus causing premature cell destruction.2 Intramedullary hemolysis along with the decreased survival of adult erythrocytes in the peripheral blood cause anemia, which in turn stimulates ineffective dyserythropoiesis. Bone marrow expansion, bone complications, and iron overload are the major causes of morbidity and early death in β-thalassemic patients.
Despite a marked increase in patient survival in recent years, treatment of β-thalassemia remains a challenging issue. Management relies on blood transfusions and iron chelation therapy. Both are cumbersome and expensive and require sustained patient compliance. Patients with Cooley's anemia (thalassemia major, TM), the most severe form of the disease, are strictly transfusion-dependent, while patients with milder phenotypes (thalassemia intermedia, TI) do not need regular transfusions. Although bone marrow transplantation can cure the disease,3 it is often not an option.4
Reactivation of fetal hemoglobin (HbF synthesis) would be a reasonable approach to improving globin chain balance in β-thalassemia. Induction of HbF synthesis in adult cells has been observed under stress erythropoiesis conditions that trigger kinetics of rapid erythroid regeneration.5 In vitro, the formation of HbF-containing cells is enhanced by erythropoietin (Epo) and by culture conditions favoring the proliferation of less differentiated progenitors.6,7 In vivo, expansion of HbF-programmed progenitors and increased HbF synthesis were observed in baboons receiving high doses of recombinant human Epo (rHuEpo) during a period of several days.8 However, long-term trials with rHuEpo gave ambiguous results in β-thalassemic patients.9-13 The treatment (perhaps with the exception of combination therapy, which included hydroxyurea14) did not increase HbF significantly, although a clinical benefit was nevertheless observed in some patients. High doses of rHuEpo were well tolerated, but there are several potential drawbacks to its use. The drug is expensive, which will limit the use of rHuEpo worldwide, and there is a theoretical risk of worsening bone marrow expansion and bone disease.
Efficient induction of fetal erythropoiesis in short-term in vitro assays or by short-term in vivo stimulation with rHuEpo contrasts with limited efficacy in long-term trials in β-thalassemic patients. This suggests that the stimulation of erythroid progenitors, which can be programmed to HbF synthesis, could become inoperative over time. To examine this point, we set up an experiment in which high amounts of murine Epo were delivered during a period of several months to β-thalassemic mice. This was achieved by adeno-associated virus–mediated (AAV-mediated) gene transfer of the mouse Epo complementary DNA (cDNA), as previously documented in normal mice.15-19 Homozygous β-thalassemic mice have a microcytic, hypochromic anemia; highly dysmorphic red blood cells (RBCs); and extensive intramedullar and intrasplenic destruction of erythroid progenitors and erythroid hyperplasia.20 Similar abnormalities in membrane functions have been documented in murine and human β-thalassemias.21 Although β-minor globin is expressed at a significant level in the adult mouse, expression is much lower than in the fetus.22,23 As for primate HbF, synthesis of β-minor increases in response to in vitro culture of erythroid progenitors,24 under stress erythropoiesis conditions,25 during hydroxyurea treatment,26and transiently in mice injected with high doses of rHuEpo.27 We show that a sustained secretion of high amounts of Epo stimulated β-minor chain synthesis over several months in β-thalassemic mice stably improved erythropoiesis.
Materials and methods
Vector preparation and administration
The AAV-CMV(cytomegalovirus)-Epo plasmid was obtained by inserting a 630–base pair (630-bp) DNA fragment containing the murine Epo coding sequence between the human CMV immediate early promoter/enhancer and the bovine growth hormone gene polyadenylation signal in pSUB-201.28 A vector stock containing 1.2 × 1011 genomes/mL was generated by a triple plasmid transfection of 293 cells, as previously described.29 Infectious particles included 5.4 × 1010 Epo-encoding U/mL, less than 5 × 102 particle-forming U/mL replicative adenovirus, and 5 × 104 Rep-transcomplementing U/mL. The preparation was injected in ether-anesthetized C57Bl/6 Hbbth mice, 3-4 months old (bred from animals obtained at the Jackson Laboratory, Ann Harbor, ME), either in both tibialis anterior muscles (200 μL total, mice Nos. 1, 2, 3, 6, 11, and 12) or in both tibialis anterior and both hind limb muscles (400 μL total, mice Nos. 4, 5, 7, 8, 9, and 10).
Hematology and Epo detection
Hemoglobin, hematocrit (Hct), and RBC counts were determined by standard procedures. Reticulocytes were counted after staining with brilliant cresyl blue. Serum Epo concentrations were measured by radioimmunoassay (Biomérieux, Charbonnier les Bains, France).
Globin chains
Synthesis was analyzed by metabolic labeling. Blood cells were washed and resuspended in methionine- and cystein-free RPMI 1640 medium with 4% dialyzed fetal calf serum for 30 minutes at 37°C before a 20-minute labeling with 9.25 MBq (250 μCi) of 35S(sulfur 35)/methionine/cystein (Amersham Life Science, Arlington Heights, IL) and a 1-hour chase. Protein extracts (50 μg) were prepared in 0.5% Triton X-100, 20 mmol/L HEPES (4-(2-hydroxyethyl)-1-piperazineethanesulfonic acid), and 150 mmol/L sodium chloride (NaCl) and were analyzed on urea-Triton-polyacrylamide gel electrophoresis. Gels were stained for 1 hour with Coomassie Brilliant Blue, then fixed and dried for quantification on a PhosphorImager (Molecular Dynamics, Sunnyvale, CA). Erythrocyte ghost extracts were prepared as described.30
Iron 59 uptake
After a 2-hour fast, mice were injected in the tail vein with 0.028 MBq (0.75 μCi) of 59Fe (ferrous sulfate in 0.1 mL 5% dextrose and water) (New England Nuclear, Boston, MA). Plasma samples taken at regular intervals over 20-50 minutes were counted in a Gamma Berthold scintillation spectrometer (Berthold, Colombes, France). Mice were sacrificed 1 hour later, and spleens were fixed with 4% paraformaldehyde overnight at 4°C. Radioactivity was measured on 16-μm thick cryosections using a β-imaging apparatus (Biospace, Paris, France).
Statistics
Statistics were performed using SPSS 6.1 software (SPSS, Chicago, IL). Significance level of linear regression square coefficients (Rsq) was estimated by F tests.
Results
Transduction of skeletal muscles
A recombinant AAV vector (rAAV) containing the mouse Epo cDNA inserted downstream of a human CMV promoter was constructed (rAAV-CMV-Epo, Figure 1A) and injected in the leg muscles of 12 β-thalassemic and 6 heterozygous C57BL/6 mice. Animals received between 2.4 × 1010 and 4.8 × 1010 physical rAAV particles. Intense polycythemia resulted in the death of treated heterozygous mice within 2 months following injection. β-Thalassemia mice were monitored for up to 1 year. With the exception of mice Nos. 9 and 12, which both died of hemorrhage a few hours after a blood sampling, the entire injected muscles were resected at the time of sacrifice, weighted, and used to prepare high-molecular-weight DNA. Southern blot hybridization with an Epo probe revealed double-stranded rAAV vector genomes representing an average proportion of 2.8%-7% of diploid mouse genomes (Figure 1B). A search for rAAV-CMV-Epo vector genomes by polymerase chain reaction (PCR) was negative in the liver, spleen, lung, and kidney (data not shown). Index values aimed at comparing the total amounts of transduced tissue between mice were calculated by multiplying the mass of the injected muscles by the proportion of vector genomes in these muscles. Data from mice Nos. 1, 2, 3, 4, 7, and 8, which were followed up for 10 to 12 months and fully investigated at the time of sacrifice, are shown in Table 1.
Quantification of rAAV-CMV-Epo vector genomes in the muscles of injected β-thalassemic mice.
(A) The vector diagram: ITR indicates AAV-2 inverted terminal repeats; CMV, immediate early promoter/enhancer elements from CMV; mEpo, murine erythropoietin; and bGH polyA, polyadenylation signal of the bovine growth hormone gene. The BamH-I fragment used as a probe is indicated. (B) Southern blot analysis of BamH-I–digested high-molecular-weight DNA extracted from injected muscle. Analysis was performed after injection at 2 months (mice Nos. 5 and 6), 5 months (mouse No. 11), 10 months (mice Nos. 3 and 10), and 1 year (mice Nos. 1, 2, 4, 7, and 8). Reference copy numbers (ref. copy numbers) correspond to 1 copy (20 pg, lane 1) or 0.1 copy (2 pg, lane 0.1) of the AAV-CMV-Epo plasmid DNA. Endogenous Epo (Epo endo.) and vector signals are shown. Quantification of vector genome copies was performed with a PhosphorImager (Molecular Dynamics) according to the ref. copy number and Epo endo. signals.
Quantification of rAAV-CMV-Epo vector genomes in the muscles of injected β-thalassemic mice.
(A) The vector diagram: ITR indicates AAV-2 inverted terminal repeats; CMV, immediate early promoter/enhancer elements from CMV; mEpo, murine erythropoietin; and bGH polyA, polyadenylation signal of the bovine growth hormone gene. The BamH-I fragment used as a probe is indicated. (B) Southern blot analysis of BamH-I–digested high-molecular-weight DNA extracted from injected muscle. Analysis was performed after injection at 2 months (mice Nos. 5 and 6), 5 months (mouse No. 11), 10 months (mice Nos. 3 and 10), and 1 year (mice Nos. 1, 2, 4, 7, and 8). Reference copy numbers (ref. copy numbers) correspond to 1 copy (20 pg, lane 1) or 0.1 copy (2 pg, lane 0.1) of the AAV-CMV-Epo plasmid DNA. Endogenous Epo (Epo endo.) and vector signals are shown. Quantification of vector genome copies was performed with a PhosphorImager (Molecular Dynamics) according to the ref. copy number and Epo endo. signals.
Data from untreated and treated β-thalessmic mice followed for 10-12 months and investigated at time of sacrifice
| . | Untreated . | Treated, Nos. . | ||||||
|---|---|---|---|---|---|---|---|---|
| +/− . | −/− . | 1 . | 2 . | 3 . | 4 . | 7 . | 8 . | |
| Index value of the amount of transduced muscle | 0 | 0 | 6.6 | 10 | 12 | 16.8 | 23.4 | 18 |
| Mean serum Epo concentration, mU/mL* | 39.2 ± 8.4 | 150 ± 37 | 265 ± 69 | 274 ± 57 | 352 ± 40 | 498 ± 77 | 617 ± 17 | 1279 ± 92 |
| Mean Hct, %* | 45.6 | 29.7 | 44.7 | 48 | 62.6 | 58.4 | 69.8 | 75.4 |
| Mean Hb, g/dL* | 15.6 | 8.6 | 13 | 13.4 | 17.3 | 16.2 | 19.9 | 22 |
| Mean corpuscular Hb content, pg/dL* | 34 | 29 | 29 | 28 | 27.8 | 27.7 | 28 | 29 |
| Mean RBC count, ×109 cells/dl* | 10 | 9.3 | 11.6 | 13 | 15 | 15 | >16 | >16 |
| Mean globular volume, fL* | 45 | 32 | 38 | 37 | 41.7 | 36 | — | — |
| Mean corpuscular Hb, pg/cell* | 15 | 9 | 11.2 | 10 | 11.5 | 10.8 | — | — |
| β-minor/α-chain in blood, % | 0.21 ± 0.03 | 0.67 | 0.85 | 0.87 | 0.91 | 0.84 | 0.84 | 0.99 |
| α-chain content in erythrocyte membrane, % of −/− | 5 ± 2 | 100 | 60 | 55 | 47.5 | 56 | 52.4 | 32.8 |
| Spleen weight, mg | 96 ± 3.6 | 577 ± 36 | 582 | 520 | 892 | 850 | 952 | 941 |
| 59Fe half-life in serum, min | 46 ± 6.1 | 21 ± 2.8 | 37 | 33 | 19 | 19 | 14 | 10 |
| . | Untreated . | Treated, Nos. . | ||||||
|---|---|---|---|---|---|---|---|---|
| +/− . | −/− . | 1 . | 2 . | 3 . | 4 . | 7 . | 8 . | |
| Index value of the amount of transduced muscle | 0 | 0 | 6.6 | 10 | 12 | 16.8 | 23.4 | 18 |
| Mean serum Epo concentration, mU/mL* | 39.2 ± 8.4 | 150 ± 37 | 265 ± 69 | 274 ± 57 | 352 ± 40 | 498 ± 77 | 617 ± 17 | 1279 ± 92 |
| Mean Hct, %* | 45.6 | 29.7 | 44.7 | 48 | 62.6 | 58.4 | 69.8 | 75.4 |
| Mean Hb, g/dL* | 15.6 | 8.6 | 13 | 13.4 | 17.3 | 16.2 | 19.9 | 22 |
| Mean corpuscular Hb content, pg/dL* | 34 | 29 | 29 | 28 | 27.8 | 27.7 | 28 | 29 |
| Mean RBC count, ×109 cells/dl* | 10 | 9.3 | 11.6 | 13 | 15 | 15 | >16 | >16 |
| Mean globular volume, fL* | 45 | 32 | 38 | 37 | 41.7 | 36 | — | — |
| Mean corpuscular Hb, pg/cell* | 15 | 9 | 11.2 | 10 | 11.5 | 10.8 | — | — |
| β-minor/α-chain in blood, % | 0.21 ± 0.03 | 0.67 | 0.85 | 0.87 | 0.91 | 0.84 | 0.84 | 0.99 |
| α-chain content in erythrocyte membrane, % of −/− | 5 ± 2 | 100 | 60 | 55 | 47.5 | 56 | 52.4 | 32.8 |
| Spleen weight, mg | 96 ± 3.6 | 577 ± 36 | 582 | 520 | 892 | 850 | 952 | 941 |
| 59Fe half-life in serum, min | 46 ± 6.1 | 21 ± 2.8 | 37 | 33 | 19 | 19 | 14 | 10 |
The mean ± SEM of measures performed in at least 3 untreated control animals.
Indicates that the mean ± SEM of these values were collected over the last 6 months of life. SEMs less than 5% of the value are not shown.
Systemic Epo delivery
Serum Epo concentrations were measured monthly (Figure2A). Mean values were much higher in untreated β-thalassemic mice (150 ± 37 mU/mL) than in heterozygous controls (39.2 ± 8.4 mU/mL). Three months after vector injection, concentrations in treated β-thalassemic mice ranged between 150-1600 mU/mL. Mean serum Epo concentrations were calculated over the last 6 months of life for mice Nos. 1, 2, 3, 4, 7, and 8 (Table 1). Values ranked with the indexes representing the amount of transduced tissue (r = 0.943; P = .005, Spearman rank correlation coefficient).
Correction of hematologic values in treated β-thalassemic mice.
(A) Serum Epo concentration, (B) Hct, (C) Hb concentration, and (D) the proportion of reticulocytes were measured monthly in treated β-thalassemic mice (continuous lines), 3 untreated β-thalassemic controls (dotted lines), and 3 heterozygous controls (dashed lines). Values correspond to individually treated mice indicated by numbers or are the mean ± SEM (standard error of the mean) for controls.
Correction of hematologic values in treated β-thalassemic mice.
(A) Serum Epo concentration, (B) Hct, (C) Hb concentration, and (D) the proportion of reticulocytes were measured monthly in treated β-thalassemic mice (continuous lines), 3 untreated β-thalassemic controls (dotted lines), and 3 heterozygous controls (dashed lines). Values correspond to individually treated mice indicated by numbers or are the mean ± SEM (standard error of the mean) for controls.
Correction of anemia
Hematocrit and Hb concentrations showed severe anemia in untreated β-thalassemic mice (Hct: 29.7% ± 1.3%; Hb: 86 ± 9.0 g/L [Hb: 8.6 ± 0.9 g/dL]; Figure 2B and 2C). Red cell morphology showed marked anisocytosis and target cells (Figure3). Hematocrits reached normal values within 1 to 2 months after vector injection in all treated β-thalassemic mice. Later on, circulating RBCs either increased further, which lead to intense polycythemia in mice Nos. 7 through 12 or stabilized to moderate polycythemia in mice Nos. 3 and 4, or remained in the normal range in mice Nos. 1 and 2 (Figure 2B and 2C). Red cell morphology was dramatically improved in all animals (Figure3). However, faint staining of blood smears suggested persistent hypochromia, which was confirmed by low mean corpuscular Hb content (Table 1). Plasma iron concentration was measured at 8 months in mouse No. 2 and found to be in the normal range (32.4 versus 34.2 ± 7 μmol/L in heterozygous controls). Mean Hct and Hb values calculated over the last 6 months of life for mice Nos. 1, 2, 3, 4, 7, and 8 were proportional to serum Epo concentrations (Table 1; Hct: Rsq = 0.726,P = .031; Hb: Rsq = 0.749, P = .026) and with indexes of transduced tissue (Hct: Rsq = 0.740, P = .028; Hb: Rsq = 0.692, P = .040). These data indicated that gene transfer and high serum Epo concentrations were directly related to the appearance of an effective erythropoiesis in treated mice.
Improvement of peripheral red blood cell morphology in treated β-thalassemic mice.
May-Grünwald Giemsa staining of blood smears from an untreated heterozygous mouse, from an untreated β-thalassemic mouse, and from the β-thalassemic mouse No. 1 twelve months after intramuscular injection of the rAAV-CMV-Epo vector.
Improvement of peripheral red blood cell morphology in treated β-thalassemic mice.
May-Grünwald Giemsa staining of blood smears from an untreated heterozygous mouse, from an untreated β-thalassemic mouse, and from the β-thalassemic mouse No. 1 twelve months after intramuscular injection of the rAAV-CMV-Epo vector.
Improvement of globin chain imbalance
Globin chain synthesis was investigated by metabolic labeling of blood cells followed by denaturing gel electrophoresis. Quantification of the β-minor to α-globin chain signal ratio showed significant improvement in mice Nos. 1, 2, 3, 4, 7, and 8 compared with 3 untreated β-thalassemic mice (Table 1; P = .005, Student ttest). However, the ratio never reached 1, indicating that unmatched α-globin chains persisted in the erythrocytes of all treated mice.
Incorporation of unpaired α-globin chains in erythrocyte membranes causes membrane abnormalities which account for the early destruction of erythroid precursors.31 We therefore analyzed the α-globin chain content in protein extracts from erythrocyte ghosts of untreated and treated mice. Results showed a 2- to 3-fold reduction of α-globin chain in erythrocyte ghosts of treated β-thalassemic mice (Table 1). Nevertheless, membrane α-globin chains were still much more abundant than in nonthalassemic mice. Consistently with the involvement of membrane α-globin chains in cell destruction, reduction was more pronounced in mice with higher values of Hct (Rsq = 0.657, P = .050) and Hb (Rsq = 0.716,P = .034). A significant relationship was also found between the reduction of membrane α-globin chains and serum Epo concentrations (Rsq = 0.786, P = .019). In addition to the dramatic changes observed in RBC morphology (Figure 3), these data suggested that high serum Epo concentrations stimulated the production of qualitatively improved RBC.
Erythroid hyperplasia and cell proliferation
A decreased proportion of reticulocytes in the blood of treated β-thalassemic mice suggested that erythroid cell proliferation was reduced rather than accelerated in response to Epo secretion (Figure2D). However, although the proportion of reticulocytes was reduced, absolute reticulocyte counts remained elevated with respect to the increased blood mass, even in normocythemic mice (10 and 9.8 × 105/μL in mice Nos. 1 and 2, respectively, versus 3.1 ± 0.4 × 105/μL in heterozygous controls). Together with the persistence of a splenomegaly (Table 1), these data suggested that erythropoiesis was still very active in treated mice.
To investigate erythroid proliferation more accurately, we examined the uptake of 59Fe in erythroid tissues and its half-life in the serum of treated mice and controls. The uptake of 59Fe in tissues was assessed by scanning fixed erythroid tissue sections with a β-imager. Data from spleen sections are shown in Figure4A. Similar data were obtained in the bone marrow and the liver (data not shown). Imaging revealed an almost total disappearance of actively regenerating foci in the spleen of treated β-thalassemic mice. Numbers of cpm/surface unit were higher in untreated β-thalassemic spleen than in heterozygotes, and they were significantly reduced in treated mice (P < .0001, Student t test). A significant relationship between decreased uptake of 59Fe uptake in spleen sections and decreased amounts of α-globin chain content in erythrocyte membranes (Rsq = 0.792, P = .018) indicated that the qualitative improvement of RBCs was associated with a diminution of erythroid cell proliferation.
Erythroid cell proliferation measured by 59Fe uptake assay.
Treated β-thalassemic mice (continuous lines), untreated β-thalassemic controls (n = 3, dotted lines), and heterozygous controls (n = 3, dashed lines) were injected with 0.028 MBq (0.75 μCi) of 59Fe in the tail vein. (A) Radioactivity in spleen sections (β-imager exposure, 755 minutes). Values are the mean ± SEM of counted cpm/mm2 on 8 sections (treated mice), 29 sections (untreated controls), and 38 sections (heterozygote controls). Values scored in mice Nos. 4 and 7 were 551 ± 56 and 711 ± 67, respectively (not shown). Gradation color indicates local radioactivity, according to the scale. (B) Kinetics of the disappearance of radioactivity in plasma. Values correspond to individually treated mice, indicated by number, or are the mean ± SEM for controls.
Erythroid cell proliferation measured by 59Fe uptake assay.
Treated β-thalassemic mice (continuous lines), untreated β-thalassemic controls (n = 3, dotted lines), and heterozygous controls (n = 3, dashed lines) were injected with 0.028 MBq (0.75 μCi) of 59Fe in the tail vein. (A) Radioactivity in spleen sections (β-imager exposure, 755 minutes). Values are the mean ± SEM of counted cpm/mm2 on 8 sections (treated mice), 29 sections (untreated controls), and 38 sections (heterozygote controls). Values scored in mice Nos. 4 and 7 were 551 ± 56 and 711 ± 67, respectively (not shown). Gradation color indicates local radioactivity, according to the scale. (B) Kinetics of the disappearance of radioactivity in plasma. Values correspond to individually treated mice, indicated by number, or are the mean ± SEM for controls.
The half-life of 59Fe in the serum was shorter in untreated β-thalassemic mice than in heterozygous mice, accounting for erythroid cell hyperproliferation (Figure 4B). Various kinetics were observed in treated β-thalassemic mice. In polycythemic mice Nos. 7 and 8, the disappearance of 59Fe from plasma was even more rapid than in untreated β-thalassemic mice. In contrast, normocythemic mice Nos. 1 and 2 showed values almost equivalent to heterozygotes. Mice Nos. 3 and 4, which had an intermediate phenotype, showed intermediate values. Table 1 shows that the half-life of59Fe in serum was inversely related to polycythemia (Hct: Rsq = 0.956, P = .001; Hb: Rsq = 0.849,P = .009) and spleen weight (Rsq = 0.915,P = .003). These data indicated that the persistence of an intense erythroid proliferation in treated mice was related to the overstimulation of an effective erythropoiesis by Epo overdosage and to the persistence of splenomegaly.
Discussion
AAV-derived vectors provide a simple method for introducing and expressing cDNA into mouse skeletal muscle.15,17-19,32Although double-stranded AAV genomes probably remain extrachromosomal in mouse myofibers, thereby forming large circularized concatemers, their tight association with chromatin allows persistence and stable expression during periods of several months.33 We took advantage of the unique properties of AAV vectors for introducing a transcription unit in which the mouse Epo cDNA was strongly expressed from human CMV enhancer and promoter elements into the skeletal muscles of β-thalassemic mice. A robust secretion of Epo was induced in all animals and persisted at the same level during the 1-year observation period, leading to high serum Epo concentrations. Increased serum Epo concentrations had major consequences on erythropoiesis in β-thalassemic mice. These consequences included a qualitative improvement of RBC phenotype, which allows for a stable correction of anemia. Probably as a result of more effective erythropoiesis, cell proliferation was reduced in erythroid tissues, as shown by the lower proportion of reticulocytes in the circulating blood (albeit not reaching normal mouse values) and by diminished 59Fe incorporation in erythroid tissues, which was inversely proportional to serum Epo concentrations. A reduced proportion of circulating reticulocytes was previously observed in mice transiently receiving high doses of rHuEpo,27 whereas contradictory data have been reported from β-thalassemic patients enrolled in rHuEpo trials.9-13
The improved quality of erythroid cells was obvious on blood smears of treated β-thalassemic mice. Anisocytosis and poikilocytosis were much less intense, and target cells were rare. However, some degree of abnormality persisted, and hypochromia was not corrected. Morphological changes were associated with modifications in RBC membrane proteins and especially with decreased amounts of α-globin chains associated with erythrocyte membranes. A relationship between serum Epo concentrations and the reduction of membrane-bound α-globin chains as well as a relationship between this latter parameter and the correction of anemia could be demonstrated. Therefore more effective erythropoiesis in treated mice was associated with an improved RBC phenotype. Previous studies have pointed out the major role of membrane protein abnormalities in ineffective erythropoiesis.2
The significant increase of β-minor chain synthesis and the subsequent reduction of unpaired α-globin chains incorporated into membranes probably played an important role in improving RBC phenotype. This was likely a consequence of the action of Epo at the level of primitive erythroid progenitors, as previously demonstrated for primates.8 Indeed, as similarly observed for the synthesis of HbF in the human erythroid lineage,34,35 β-minor is produced to higher levels in the progeny of primitive erythroid progenitors,24 which increases in frequency in vivo in response to erythroid stress,25 hydroxyurea,26and rHuEpo.27 In primates, the increased proportion of F cells (cells containing HbF) under these conditions is thought to result either from a premature commitment of primitive progenitors recruited before completion of γ gene inactivation or from a faster cycling, which impairs completion of inactivation.8 In mouse erythroid cell cultures36 and in vivo in baboons,8 induction by Epo results from the expansion of BFU-e, which has the potential to form β-minor or fetal Hb, rather than from late erythroid precursors, which are committed to β-major or HbA. In β-thalassemic mice under strong Epo stimulation, the preferential mobilization of BFU-e programmed for β-minor synthesis may account for the observed emergence of an effective erythropoiesis, which slowed down erythroid cell proliferation, whereas the expansion of late erythroid progenitors, which would aggravate dyserythropoiesis, remained absent or limited. The expansion of a pool of primitive erythroid progenitors has been previously reported in untreated β-thalassemic mice37 and in β-thalassemic patients.38 Interestingly, the possibility of inducing a stable hypersecretion of autologous Epo over the long term in β-thalassemic mice indicated that effective erythropoiesis was sustained in treated animals for at least 1 year.
If the model discussed above is correct, sustained improvement of erythropoiesis suggests that a chronic expansion of the primitive BFU-e compartment can be induced in mice continuously secreting high amounts of Epo. Investigations of Epo-responding erythroid progenitors in β-thalassemic mice treated with the AAV-CMV-Epo vector are currently being performed. In preliminary unpublished experiments, we used different gene transfer methods to obtain sustained Epo secretion in β-thalassemic mice. Serum Epo concentration was significantly lower than those reported in the present study using AAV-mediated gene transfer. These attempts led to a transient and partial improvement of erythropoiesis, which was observed in a minority of treated animals only, without significant reduction of dyserythropoiesis. Similar observations have been reported by Dalle et al39 using a cell encapsulation method. This situation may be somehow reminiscent of rHuEpo trials in human patients, which led to partial and inconsistent improvements. It may be assumed that chronic expansion of the primitive BFU-e compartment requires an intense and sustained stimulation in order to be effective. The observed synergistic effects of rHuEpo and hydroxyurea in β-thalassemic patients support this hypothesis.14
Although the reduction of erythroid cell proliferation was present in all treated mice, 59Fe incorporation and half-life in serum were comparable to those of normal mice only in normocythemic animals, in which serum Epo concentrations remained between 250 and 350 mU/mL. Higher concentrations resulted in the expansion of phenotypically improved RBCs and in subsequent polycythemia (Figure5). This result points out the need for a regulated expression system which allows for control of Epo secretion from engineered cells, such as that previously implemented in normal mice and nonhuman primates.17-19 The reduction of erythroid cell proliferation was also limited by splenomegaly, which persisted in all treated animals 1 year after anemia had been corrected. The reasons for the persistence of splenomegaly are unclear. Combination therapies with hydroxyurea or splenectomy could be considered, with the aim of facilitating control of erythroid cell proliferation in β-thalassemic mice.
Schematic representation of the effects of serum Epo concentration on the erythropoiesis of treated β-thalassemic mice.
Schematic representation of the effects of serum Epo concentration on the erythropoiesis of treated β-thalassemic mice.
The successful treatment of murine disease following intramuscular injection of the AAV-CMV-Epo vector raises questions about the relevance of this method for human β-thalassemia. Gene therapy trials with rAAV vectors are currently ongoing in hemophiliac patients. Regulated expression systems may be considered for human application in the near future. More concerns exist with respect to the clinical benefits that may be expected from Epo therapy in human β-thalassemia because trials with rHuEpo produced ambiguous results.9-13On the other hand, these trials indicate that high doses of rHuEpo did not induce unwanted side effects. Cost, which is an obvious limitation to treatments with rHuEpo, is potentially lower with a gene therapy approach. Because rHuEpo seems at least to provide clinical benefit in certain subpopulations of β-thalassemic patients, Epo gene therapy could be considered for long-term treatment in selected patients who have demonstrated unambiguous responsiveness to rHuEpo during a preliminary short-term trial.
Acknowledgments
We are grateful to Dr G. Millon for help in the 59Fe uptake experiments, to Dr Y. Beuzard for helpful discussions during the origin of this work, and to Drs G. Stamatoyannopoulos and F. Mavilio for critical reading of the manuscript.
Supported by grant number 5902 from the Association Française contre la Myopathie, Paris, France. D.B. is a fellow from Caisse Nationale d'Assurance Maternité (CANAM), Paris, France. A.B. is a fellow from the European Commission (DG XII), Brussels, Belgium.
Reprints:Jean Michel Heard, Laboratoire Rétrovirus et Transfert Génétique, Institut Pasteur, 28 rue du Dr Roux, 75724 Paris, France; e-mail: jmheard@pasteur.fr.
The publication costs of this article were defrayed in part by page charge payment. Therefore, and solely to indicate this fact, this article is hereby marked “advertisement” in accordance with 18 U.S.C. section 1734.

This feature is available to Subscribers Only
Sign In or Create an Account Close Modal